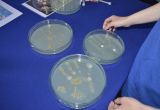
20 piknik naukowy 010

Pisać tajne wiadomości niewidzialnym atramentem, poszukiwać magicznych przeciwutleniaczy w napojach, zbadać szczątki polskich dinozaurów, eksperymentować w laboratorium chemicznym, projektować żelkowe DNA, tworzyć kosmetyki z liofilizowanych owoców, budować gigantyczne bakterie i poznać technikę widzenia w całkowitej ciemności. Z tymi i wieloma innymi zadaniami zmierzą się goście Rodzinnego Pikniku Polskiej Akademii Nauk „Nauka też sztuka!”, który odbędzie się już w sobotę 10 czerwca wokół sceny staromiejskiej w Olsztynie.
To już trzecia edycja Pikniku organizowanego przez Instytut Rozrodu Zwierząt i Badań Żywności PAN w Olsztynie wspólnie z Miejskim Ośrodkiem Kultury. Popularno-naukowe pokazy, warsztaty, eksperymenty i konkursy są znakomitą okazją do przyjrzenia się pracy badaczy, spróbowania swoich sił w naukowych wyzwaniach i rozbudzenia w sobie pasji odkrywania otaczającego nas świata. A w tym roku na gości będzie czekało jeszcze więcej atrakcji niż do tej pory. Organizatorzy zaprosili do Olsztyna zaprzyjaźnionych naukowców z innych jednostek Polskiej Akademii Nauk z całej Polski, m.in. z Instytutu Biochemii i Biofizyki, Instytutu Chemii Organicznej czy Instytutu Paleobiologii, dzięki którym przyjrzymy się polskim badaniom na Antarktyce, zbadamy kości sprzed 230 milionów lat i nauczymy się „chodzić po wodzie”. Swoje pokazy przygotują też badacze z Uniwersytetu Warszawskiego i Wydziału Leśnego Uniwersytetu Przyrodniczego w Poznaniu, podczas których nauczymy się przeprowadzać eksperymenty za pomocą najprostszych produktów spożywczych i poznamy niełatwą sztukę poruszania się po lesie.
Nie zabraknie też „bestsellerów” prowadzonych przez naukowców z Instytutu Rozrodu Zwierząt i Badań Żywności PAN. Organizatorzy przygotują m.in. warsztaty komponowania kosmetyków z dodatkiem liofilizowanych owoców, konkurs sprawdzający sprawność naszych zmysłów, eksperymenty pozwalające wykryć w żywności korzystne dla naszego zdrowia antyoksydanty, warsztaty budowania DNA ze słodkich żelków i zawody poszukiwania glutenu w produktach z naszego codziennego menu.
Piknik Polskiej Akademii Nauk „Nauka też Sztuka” rozpocznie się o godz. 12:00 na scenie staromiejskiej w Olsztynie i potrwa do godz. 16:00, Wstęp wolny!
Organizator: Instytut Rozrodu Zwierząt i Badań Żywności PAN w Olsztynie
Współorganizator: Miejski Ośrodek Kultury
Partner: Oddział Polskiej Akademii Nauk w Olsztynie i Białymstoku z siedzibą w Olsztynie
Dołącz do wydarzenia na Facebooku